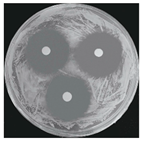
Ijms 26 07371 i008
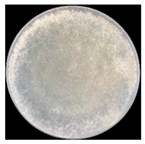
Ijms 26 07371 i009
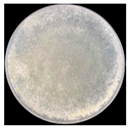
Ijms 26 07371 i010

A Simple and Rapid Synthesis of Spherical Silver Phosphate (Ag3PO4) and Its Antimicrobial Activity in Plant Tissue Culture
Abstract
1. Introduction
2. Results and Discussion
2.1. Physicochemical Characteristics of Ag3PO4
2.1.1. Functional Group of Ag3PO4
2.1.2. Crystal Structure of Ag3PO4
2.1.3. Morphology of Ag3PO4
2.1.4. Chemical Composition of Ag3PO4
2.2. Antimicrobial Performance of Ag3PO4
2.2.1. Isolation and Identification of Contaminants
2.2.2. Antimicrobial Activity Result
3. Materials and Methods
3.1. Synthesis and Characterization of Ag3PO4
3.1.1. Starting Materials
3.1.2. Ag3PO4 Preparation
3.1.3. Characterization of Ag3PO4
3.2. Antimicrobial Activity of Ag3PO4
3.2.1. Isolation of Contaminating Microorganisms from Aquatic Plant Tissue Culture
3.2.2. Molecular Microbial Identification
3.2.3. Antimicrobial Activity Test
4. Conclusions
Author Contributions
Funding
Institutional Review Board Statement
Informed Consent Statement
Data Availability Statement
Acknowledgments
Conflicts of Interest
References
- Chukwu, S.C.; Awala, S.; Angombe, S.; Valombola, J.; Nanhapo, P.; Mberama, C.; Rafii, M.Y.; Oladosu, Y.; Thomas, B.; Okporie, E.O. Recent progress in tissue culture techniques and biotechnological innovations for banana production (Musa spp.): A review. Discov. Plants 2025, 2, 13. [Google Scholar] [CrossRef]
- Sudheer, W.; Praveen, N.; Al-Khayri, J.; Jain, S. Role of Plant Tissue Culture Medium Components. In Advances in Plant Tissue Culture; Elsevier: Amsterdam, The Netherlands, 2022; pp. 51–83. [Google Scholar] [CrossRef]
- Teixeira da Silva, J.A.; Kulus, D.; Zhang, X.; Zeng, S.; Ma, G.; Piqueras, A. Disinfection of explants for saffron (Crocus sativus) tissue culture. Environ. Exp. Bot. 2016, 14, 183–198. [Google Scholar] [CrossRef]
- Modi, A.; Kumar, A. Microbes as biostimulants: Tissue culture prospective. In Microbiome Stimulants for Crops; Elsevier: Amsterdam, The Netherlands, 2021; pp. 239–251. [Google Scholar] [CrossRef]
- Wang, L.; Zhang, X.; Lu, J.; Huang, L. Microbial diversity and interactions: Synergistic effects and potential applications of Pseudomonas and Bacillus consortia. Microbiol. Res. 2025, 293, 128054. [Google Scholar] [CrossRef]
- Bunn, E.; Tan, B. Microbial Contaminants in Plant Tissue Culture Propagation. In Microorganisms in Plant Conservation and Biodiversity; Springer: Dordrecht, The Netherlands, 2002; pp. 307–335. [Google Scholar] [CrossRef]
- Cassells, A.C. Pathogen and biological contamination management in plant tissue culture: Phytopathogens, vitro pathogens, and vitro pests. Methods Mol. Biol. 2012, 877, 57–80. [Google Scholar] [CrossRef] [PubMed]
- Eliwa, G.I.; El-Dengawy, E.-R.F.; Gawish, M.S.; Yamany, M.M. Comprehensive study on in vitro propagation of some imported peach rootstocks: In vitro explant surface sterilization and bud proliferation. Sci. Rep. 2024, 14, 5586. [Google Scholar] [CrossRef] [PubMed]
- Mihaljević, I.; Dugalić, K.; Tomaš, V.; Viljevac, M.; Pranjić, A.; Čmelik, Z.; Puškar, B.; Jurković, Z. In vitro sterilization procedures for micropropagation of ‘Oblačinska’sour cherry. J. Agric. Sci. (Belgr. Online) 2013, 58, 117–126. [Google Scholar] [CrossRef]
- Fukuzaki, S. Mechanisms of actions of sodium hypochlorite in cleaning and disinfection processes. Biocontrol Sci. 2006, 11, 147–157. [Google Scholar] [CrossRef]
- Yadav, A.; Prasad, Y.; Kumar, M.; Pandey, S.; Maurya, R.; Pandey, P. Effects of mercuric chloride and ethanol for surface sterilization under in vitro plant growth in banana (Musa paradisiaca L.) variety “Udhayam”. J. Pharmacogn. Phytochem. 2021, 10, 2281–2283. [Google Scholar]
- Suaib, S.; Arief, N.; Sadimantara, G.; Suliartini, N.; Rakian, T.; Ardhi, A. In vitro seeds germination and plantlets growth of hot pepper (Capsicum frutescens L.) on non-autoclaved murashige and skoog basal medium. Asian J. Plant Sci. 2018, 17, 173–181. [Google Scholar] [CrossRef]
- Li, S.; Geng, Y.; Bao, C.; Mei, Q.; Shi, T.; Ma, X.; Hua, R.; Fang, L. Complete biodegradation of fungicide carboxin and its metabolite aniline by Delftia sp. HFL-1. Sci. Total Environ. 2024, 912, 168957. [Google Scholar] [CrossRef]
- Kara, M.; Oztas, E.; Ramazanoğulları, R.; Kouretas, D.; Nepka, C.; Tsatsakis, A.M.; Veskoukis, A.S. Benomyl, a benzimidazole fungicide, induces oxidative stress and apoptosis in neural cells. Toxicol. Rep. 2020, 7, 501–509. [Google Scholar] [CrossRef]
- Rajpal, N.; Verma, S.; Kumar, N.; Lee, J.; Kim, K.-H.; Ratan, J.K.; Divya, N. Bioremediation of carbendazim and thiamethoxam in domestic greywater using a bioaugmented microbial consortium. Environ. Technol. Innov. 2023, 30, 103087. [Google Scholar] [CrossRef]
- Yu, S.; Wang, Y.; Shen, F.; Fang, H.; Yu, Y. Copper-based fungicide copper hydroxide accelerates the evolution of antibiotic resistance via gene mutations in Escherichia coli. Sci. Total Environ. 2022, 815, 152885. [Google Scholar] [CrossRef] [PubMed]
- Gammoudi, N.; Nagaz, K.; Ferchichi, A. Establishment of optimized in vitro disinfection protocol of Pistacia vera L. explants mediated a computational approach: Multilayer perceptron–multi− objective genetic algorithm. BMC Plant Biol. 2022, 22, 324. [Google Scholar] [CrossRef] [PubMed]
- Yildiz, M.; Er, C. The effect of sodium hypochlorite solutions on in vitro seedling growth and shoot regeneration of flax (Linum usitatissimum). Naturwissenschaften 2002, 89, 259–261. [Google Scholar] [CrossRef]
- Telci, C.; Yildiz, M.; Pelit, S.; Onol, B.; Erkilic, E.G.; Kendir, H. The effect of surface-disinfection process on dormancy-breaking, seed germination, and seedling growth of Lathyrus chrysanthus Boiss. under in vitro conditions. Propag. Ornam. Plants. 2011, 11, 10–16. [Google Scholar]
- Alotaibi, A.M.; Alsaleh, N.B.; Aljasham, A.T.; Tawfik, E.A.; Almutairi, M.M.; Assiri, M.A.; Alkholief, M.; Almutairi, M.M. Silver nanoparticle-based combinations with antimicrobial agents against antimicrobial-resistant clinical isolates. Antibiotics 2022, 11, 1219. [Google Scholar] [CrossRef]
- Li, H.; Xu, H. Mechanisms of bacterial resistance to environmental silver and antimicrobial strategies for silver: A review. Environ. Res. 2024, 248, 118313. [Google Scholar] [CrossRef]
- Lam, V.P.; Beomseon, L.; Anh, V.K.; Loi, D.N.; Kim, S.; Kwang-Ya, L.; Park, J. Effectiveness of silver nitrate application on plant growth and bioactive compounds in Agastache rugosa (Fisch. & CA Mey.) kuntze. Heliyon 2023, 9, e20205. [Google Scholar] [CrossRef]
- Pant, B.; Kim, A.A.; Munkhtur, E.; Park, M. Ag3PO4 particles decorated into fly-ash-incorporated electrospun polyurethane nanofibers: Simultaneously enhanced photocatalytic and antibacterial activities. Photochem 2025, 5, 6. [Google Scholar] [CrossRef]
- Paluch, E.; Seniuk, A.; Plesh, G.; Widelski, J.; Szymański, D.; Wiglusz, R.J.; Motola, M.; Dworniczek, E. Mechanism of action and efficiency of Ag3PO4-based photocatalysts for the control of hazardous gram-positive pathogens. Int. J. Mol. Sci. 2023, 24, 13553. [Google Scholar] [CrossRef] [PubMed]
- Tseng, C.S.; Wu, T.; Lin, Y.W. Facile synthesis of Ag3PO4 microcrystals and its enhanced photocatalytic disinfection. Micro Nano Lett. 2018, 13, 1570–1573. [Google Scholar] [CrossRef]
- George, E.F.; Hall, M.A.; De Klerk, G.-J. Plant Propagation by Tissue Culture 3rd Edition. Plant Cell Tissue Organ Cult. 2008, 93, 353–355. [Google Scholar] [CrossRef]
- Kalimuthu, V.; Veerakumar, P. Microwave-assisted hydrothermal synthesis of biogenic Ag3PO4@NS-rGO@AgNDs nanocomposite for pharmaceutical and photodegradation applications. Colloids Surf. A Physicochem. Eng. Asp. 2024, 703, 135242. [Google Scholar] [CrossRef]
- He, G.; Yang, W.; Zheng, W.; Gong, L.; Wang, X.; An, Y.; Tian, M. Facile controlled synthesis of Ag3PO4 with various morphologies for enhanced photocatalytic oxygen evolution from water splitting. RSC Adv. 2019, 9, 18222–18231. [Google Scholar] [CrossRef]
- Długosz, O.; Banach, M. Flow synthesis of Ag3PO4/nAg nanoparticles and its photocatalytic and antimicrobial properties. Mater. Chem. Phys. 2022, 278, 125586. [Google Scholar] [CrossRef]
- Tseng, C.-S.; Wu, T.; Lin, Y.-W. Facile synthesis and characterization of Ag3PO4 microparticles for degradation of organic dyestuffs under white-light light-emitting-diode irradiation. Materials 2018, 11, 708. [Google Scholar] [CrossRef]
- Takeno, M.L.; Nobre, F.X.; da Costa, F.F.; Botelho do Nascimento, M.V.; Pessoa, W.A.G., Jr.; Araújo Júnior, E.A.; Sousa, G.d.S.; de Sá, M.L.; Gurgel, R.S.; Albuquerque, P.M. Solvent effect on the structural, optical, morphology, and antimicrobial activity of silver phosphate microcrystals by conventional hydrothermal method. ACS Omega 2024, 9, 23069–23085. [Google Scholar] [CrossRef]
- Costa, T.M.; Lima, M.S.; Cruz Filho, J.F.; Silva, L.J.; Santos, R.S.; Luz, G.E., Jr. Synthesis, characterization, and photocatalytic activity of Ag3PO4/SBA-15 in ciprofloxacin degradation under polychromatic irradiation. J. Photochem. Photobiol. A Chem. 2018, 364, 461–471. [Google Scholar] [CrossRef]
- Moura, J.; de Abreu Lima, C.; Melo, E.; Santos, V.; Ferreira, W.; Freire, P.; Luz-Lima, C. Temperature-dependent phonon dynamics of Ag3PO4 microcrystals. Spectrochim. Acta Part A Mol. Biomol. Spectrosc. 2021, 249, 119339. [Google Scholar] [CrossRef]
- Ren, J.; Chai, Y.; Liu, Q.; Zhang, L.; Dai, W.-L. Intercorrelated Ag3PO4 nanoparticles decorated with graphic carbon nitride: Enhanced stability and photocatalytic activities for water treatment. Appl. Surf. Sci. 2017, 403, 177–186. [Google Scholar] [CrossRef]
- Šoptrajanov, B. Very low H–O–H bending frequencies. I. Overview and infrared spectra of NiKPO4·H2O and its deuterated analogues. J. Mol. Struct. 2000, 555, 21–30. [Google Scholar] [CrossRef]
- Guan, X.; Guo, L. Cocatalytic effect of SrTiO3 on Ag3PO4 toward enhanced photocatalytic water oxidation. ACS Catal. 2014, 4, 3020–3026. [Google Scholar] [CrossRef]
- Botelho, G.; Andres, J.; Gracia, L.; Matos, L.S.; Longo, E. Photoluminescence and photocatalytic properties of Ag3PO4 microcrystals: An experimental and theoretical investigation. ChemPlusChem 2016, 81, 202–212. [Google Scholar] [CrossRef]
- dos Santos, C.C.; de Assis, M.; Machado, T.R.; dos Santos Pereira, P.F.; Minguez-Vega, G.; Cordoncillo, E.; Beltran-Mir, H.; Doñate-Buendía, C.; Andres, J.; Longo, E. Proof-of-concept studies directed toward the formation of metallic Ag nanostructures from Ag3PO4 induced by electron beam and femtosecond laser. Part. Part. Syst. Charact. 2019, 36, 1800533. [Google Scholar] [CrossRef]
- Amornpitoksuk, P.; Intarasuwan, K.; Suwanboon, S.; Baltrusaitis, J. Effect of phosphate salts (Na3PO4, Na2HPO4, and NaH2PO4) on Ag3PO4 morphology for photocatalytic dye degradation under visible light and toxicity of the degraded dye products. Ind. Eng. Chem. Res. 2013, 52, 17369–17375. [Google Scholar] [CrossRef]
- Badr, L.; Epstein, I. Propagation behavior of silver hydroxide precipitate bands. Chem. Phys. Lett. 2022, 800, 139681. [Google Scholar] [CrossRef]
- Basso, M.; Furlan, C.; Colusso, E.; Sgarbossa, F.; Jasieniak, J.; Martucci, A. Influence of humidity and aging on the optimization of VO2 sol-gel thin films for thermochromic smart windows. J. Sol-Gel Sci. Technol. 2025, 1–12. [Google Scholar] [CrossRef]
- Thilagashanthi, T.; Gunasekaran, K.; Satyanarayanan, K. Microstructural pore analysis using SEM and ImageJ on the absorption of treated coconut shell aggregate. J. Clean. Prod. 2021, 324, 129217. [Google Scholar] [CrossRef]
- Febiyanto, F.; Soleh, A.; Amal, M.S.K.; Afif, M.; Sewiji, S.; Riapanitra, A.; Sulaeman, U. Facile synthesis of Ag3PO4 photocatalyst with varied ammonia concentration and its photocatalytic activities for dye removal. Bull. Chem. React. Eng. Catal. 2019, 14, 42–50. [Google Scholar] [CrossRef]
- Ma, J.; Zou, J.; Li, L.; Yao, C.; Zhang, T.; Li, D. Synthesis and characterization of Ag3PO4 immobilized in bentonite for the sunlight-driven degradation of Orange II. Appl. Catal. B Environ. 2013, 134, 1–6. [Google Scholar] [CrossRef]
- Hammoudeh, Y.; Suresh, L.; Ong, Z.Z.; Lister, M.M.; Mohammed, I.; Thomas, D.J.I.; Cottell, J.L.; Holden, J.M.; Said, D.G.; Dua, H.S. Microbiological culture versus 16S/18S rRNA gene PCR-sanger sequencing for infectious keratitis: A three-arm, diagnostic cross-sectional study. Front. Med. 2024, 11, 1393832. [Google Scholar] [CrossRef] [PubMed]
- Khan, M.S.; Gao, J.; Zhang, M.; Chen, X.; Moe, T.S.; Du, Y.; Yang, F.; Xue, J.; Zhang, X. Isolation and characterization of plant growth-promoting endophytic bacteria Bacillus stratosphericus LW-03 from Lilium wardii. 3 Biotech 2020, 10, 305. [Google Scholar] [CrossRef]
- Permadi, N.; Nurzaman, M.; Alhasnawi, A.N.; Doni, F.; Julaeha, E. Managing lethal browning and microbial contamination in Musa spp. tissue culture: Synthesis and perspectives. Horticulturae 2023, 9, 453. [Google Scholar] [CrossRef]
- Leifert, C.; Waites, W.; Nicholas, J.; Keetley, J.W. Yeast contaminants of micropropagated plant cultures. J. Appl. Microbiol. 1990, 69, 471–476. [Google Scholar] [CrossRef]
- Cobrado, J.S.; Fernandez, A.M. Common fungi contamination affecting tissue-cultured abaca (Musa textiles Nee) during initial stage of micropropagation. Asian Res. J. Agric. 2016, 1, 1–7. [Google Scholar] [CrossRef]
- Dânoun, K.; Tabit, R.; Laghzizil, A.; Zahouily, M. A novel approach for the synthesis of nanostructured Ag3PO4 from phosphate rock: High catalytic and antibacterial activities. BMC Chem. 2021, 15, 42. [Google Scholar] [CrossRef] [PubMed]
- Suresha, S.; Karthikeyanc, S.; Saravanand, P.; Jayamoorthyd, K.; Dhanalekshmi, K. Comparison of antibacterial and antifungal activity of 5-amino-2-mercapto benzimidazole and functionalized Ag3O4 nanoparticles. Karbala Int. J. Mod. Sci. 2016, 2, 129–137. [Google Scholar] [CrossRef]
- Baďurová, K.; Motola, M.; Janczura, A.; Roch, T.; Satrapinskyy, L.; Greguš, J.; Dworniczek, E.; Plesch, G. Structural transformation of Ag3PO4 and Ag3PO4/TiO2 induced by visible light and Cl− ions: Its impact on their photocatalytic, antimicrobial, and antifungal performance. Chem. Pap. 2020, 74, 2785–2797. [Google Scholar] [CrossRef]
- Bjornsdottir, K.; Breidt, F.; McFeeters, R.F. Protective effects of organic acids on survival of Escherichia coli O157:H7 in acidic environments. Appl. Environ. Microbiol. 2006, 72, 660–665. [Google Scholar] [CrossRef]
- Fraise, A.P.; Wilkinson, M.; Bradley, C.; Oppenheim, B.; Moiemen, N. The antibacterial activity and stability of acetic acid. J. Hosp. Infect. 2013, 84, 329–331. [Google Scholar] [CrossRef] [PubMed]
- Li, W.; Cao, G.; Zhu, M.; Zhang, Y.; Zhou, R.; Zhao, Z.; Guo, Y.; Yang, W.; Zheng, B.; Tan, J. Isolation, identification and pollution prevention of bacteria and fungi during the tissue culture of Dwarf Hygro (Hygrophila polysperma) explants. Microorganisms 2022, 10, 2476. [Google Scholar] [CrossRef] [PubMed]
- Xing, Y.; Liu, C.; Cui, X.; Lv, H.; Wang, J. Isolation, identification, and control of Pathogenic Endophytic fungi in Nymphaea candida Presl tissue culture. Microorganisms 2025, 13, 1103. [Google Scholar] [CrossRef]
- Luo, Z.; Chang, G.; Liu, Y.; Ni, K.; Zhou, T.; Lv, X.; Yu, J.; Bai, J.; Wang, X. Inactivation of suspended cells and biofilms of the gram-negative bacteria by electron beam irradiation and possible mechanisms of action. LWT 2022, 172, 114171. [Google Scholar] [CrossRef]
- Jiang, Y.; Ren, Y.; Xu, X.; Wang, H.; Wei, C. Application of allele specific PCR in identifying offspring genotypes of bi-allelic SbeIIb mutant lines in rice. Plants 2022, 11, 524. [Google Scholar] [CrossRef]
- Lorenz, T.C. Polymerase chain reaction: Basic protocol plus troubleshooting and optimization strategies. J. Vis. Exp. 2012, 63, e3998. [Google Scholar] [CrossRef]
- McGuire, M.J.; Li, S.; Brown, K.C. Biopanning of phage displayed peptide libraries for the isolation of cell-specific ligands. Methods Mol. Biol. 2009, 504, 291–321. [Google Scholar] [CrossRef] [PubMed]
- Rani, S.; Kataria, A.; Gupta, O.; Bhambri, P.; Min, H. nBLAST-JC: An accelerated deployment of nucleotide BLAST on high-performance cluster. Heliyon 2025, 11, e41866. [Google Scholar] [CrossRef]
- Liu, B.; Wu, H.; Cao, Y.; Ma, G.; Zheng, X.; Zhu, H.; Song, X.; Sui, S. Reducing costs and shortening the cetyltrimethylammonium bromide (CTAB) method to improve DNA extraction efficiency from wintersweet and some other plants. Sci. Rep. 2025, 15, 13441. [Google Scholar] [CrossRef]
- Azizi, M.; Dashtian, K.; Amourizi, F.; Sharifi, A.; Ghaedi, M.; Pezeshkpour, V.; Azizi, A.; Aghaee, S.; Khosravani, S.A.; Yasin, G. Antibacterial activity assessment of Bi2WO6/Ag3PO4/Ag photocatalyst and Persian Oak fruit phytobiotic. Catalysts 2022, 12, 1027. [Google Scholar] [CrossRef]
- Sánchez-Salcedo, S.; García, A.; González-Jiménez, A.; Vallet-Regí, M. Antibacterial effect of 3D printed mesoporous bioactive glass scaffolds doped with metallic silver nanoparticles. Acta Biomater. 2023, 155, 654–666. [Google Scholar] [CrossRef]
- Erhonyota, C.; Edo, G.I.; Onoharigho, F.O. Comparison of poison plate and agar well diffusion method determining the antifungal activity of protein fractions. Acta Ecol. Sin. 2023, 43, 684–689. [Google Scholar] [CrossRef]
- Rante, H.; Alam, G.; Pakki, E.; Umar, U.; Ali, A. Identification and antibacterial activity of Actinomycetes isolated from medicinal plant Andrographis Paniculata rhizosphere soil. Crescent J. Med. Biol. Sci. 2020, 7, 1–7. [Google Scholar]




| Chemical Compositions | Chemical Contents/wt% | |||
|---|---|---|---|---|
| SP-A | SP-P | |||
| Major components | Silver oxide | Ag2O | 87.2 | 84.5 |
| Phosphorus pentoxide | P2O5 | 12.7 | 13.8 | |
| Minor components | Silicon dioxide | SiO2 | 0.0250 | 0.0275 |
| Sulfur trioxide | SO3 | 0.6900 | 0.0596 | |
| Potassium oxide | K2O | – | 1.5100 | |
| Palladium oxide | PdO | 0.0261 | 0.0871 | |
| Total purities (Ag2O + P2O5) | 99.9 | 98.3 | ||
| Isolate No. | Species Recognized on BLAST (Best Hit) | GenBank Accession | Identities | Note | |
|---|---|---|---|---|---|
| Match/Total | Pct. (%) | ||||
| 1 | B. stratosphericus | NR_042336 | 1496/1498 | 99.86 | Bacteria |
| 2 | M. guilliermondii | KX258468 | 1658/1658 | 100.00 | Yeast |
| 3 | P. chrysosporium | MH047187 | 1654/1655 | 99.93 | Fungi |
| Treatments | Zone of Inhibition (mm) | Colony Diameter (mm) | ||
|---|---|---|---|---|
| Bacterial B. stratosphericus | Yeast M. guilliermondii | Fungal P. chrysosporium | ||
| Control (DI water) | 0.0 ± 0.0 a | 0.0 ± 0.0 a | 84.60 ± 0.0 b | |
| Ag3PO4 (ppm) | 5 | 0.0 ± 0.0 a | 0.0 ± 0.0 a | 84.60 ± 0.0 b |
| 10 | 6.10 ± 0.56 b | 11.83 ± 2.70 b | 0.0 ± 0.0 a | |
| 15 | 12.06 ± 1.58 c | 14.38 ± 0.80 bc | 0.0 ± 0.0 a | |
| 20 | 16.61 ± 0.26 d | 15.75 ± 0.49 c | 0.0 ± 0.0 a | |
| 25 | 17.41 ± 0.54 d | 16.70 ± 2.25 c | 0.0 ± 0.0 a | |
| 30 | 20.50 ± 1.91 e | 22.33 ± 4.23 d | 0.0 ± 0.0 a | |
| Microbials | [Acetic Acid] 30 ppm | [Ag3PO4] | ||
|---|---|---|---|---|
| 10 ppm | 20 ppm | 30 ppm | ||
| Bacterial B. stratosphericus | ![]() | ![]() | ![]() | ![]() |
| Yeast M. guilliermondii | ![]() | ![]() | ![]() | ![]() |
| [Acetic Acid] 30 ppm | [Ag3PO4] | |||
| 5 ppm | 10 ppm | 15 ppm | ||
| Fungal P. chrysosporium | ![]() | ![]() | ![]() | ![]() |
Disclaimer/Publisher’s Note: The statements, opinions and data contained in all publications are solely those of the individual author(s) and contributor(s) and not of MDPI and/or the editor(s). MDPI and/or the editor(s) disclaim responsibility for any injury to people or property resulting from any ideas, methods, instructions or products referred to in the content. |
© 2025 by the authors. Licensee MDPI, Basel, Switzerland. This article is an open access article distributed under the terms and conditions of the Creative Commons Attribution (CC BY) license (https://creativecommons.org/licenses/by/4.0/).
Share and Cite
Laohavisuti, N.; Boonchom, B.; Rungrojchaipon, P.; Boonmee, W.; Seesanong, S.; Punthipayanon, S. A Simple and Rapid Synthesis of Spherical Silver Phosphate (Ag3PO4) and Its Antimicrobial Activity in Plant Tissue Culture. Int. J. Mol. Sci. 2025, 26, 7371. https://doi.org/10.3390/ijms26157371
Laohavisuti N, Boonchom B, Rungrojchaipon P, Boonmee W, Seesanong S, Punthipayanon S. A Simple and Rapid Synthesis of Spherical Silver Phosphate (Ag3PO4) and Its Antimicrobial Activity in Plant Tissue Culture. International Journal of Molecular Sciences. 2025; 26(15):7371. https://doi.org/10.3390/ijms26157371
Chicago/Turabian StyleLaohavisuti, Nongnuch, Banjong Boonchom, Pesak Rungrojchaipon, Wimonmat Boonmee, Somkiat Seesanong, and Sirichet Punthipayanon. 2025. "A Simple and Rapid Synthesis of Spherical Silver Phosphate (Ag3PO4) and Its Antimicrobial Activity in Plant Tissue Culture" International Journal of Molecular Sciences 26, no. 15: 7371. https://doi.org/10.3390/ijms26157371
APA StyleLaohavisuti, N., Boonchom, B., Rungrojchaipon, P., Boonmee, W., Seesanong, S., & Punthipayanon, S. (2025). A Simple and Rapid Synthesis of Spherical Silver Phosphate (Ag3PO4) and Its Antimicrobial Activity in Plant Tissue Culture. International Journal of Molecular Sciences, 26(15), 7371. https://doi.org/10.3390/ijms26157371